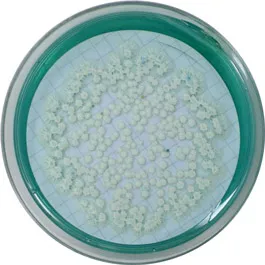

m-Green, Agar
01-633
ISO
Medio de cultivo sólido para la enumeración de hongos de acuerdo a la norma ISO 10718.
Sinónimos: m-GREEN YEAST & MOULD AGAR
ISO
Medio de cultivo sólido para la enumeración de hongos de acuerdo a la norma ISO 10718.
Sinónimos: m-GREEN YEAST & MOULD AGAR

01-633
ISO
Medio de cultivo sólido para la enumeración de hongos de acuerdo a la norma ISO 10718.
Sinónimos: m-GREEN YEAST & MOULD AGAR

Resto del Mundo
Resto del Mundo



